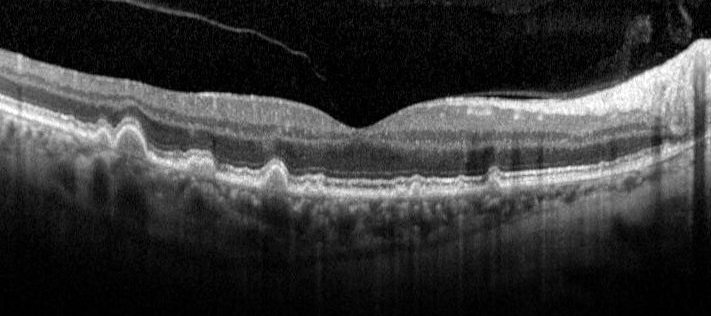

Overview

Intermediate AMD is characterised by the presence of large drusen (greater than 125µm in diameter) and/or pigmentary abnormalities (hyper or hypo-pigmentary changes associated with at least medium sized drusen). There should be no characteristics of late AMD.
On OCT imaging, drusen appear as dome-shaped elevations of the RPE. Over time, drusen can increase in size and coalesce to become confluent. Pigmentary abnormalities can present as RPE disturbance, thickening or attenuation. In cases of hyper-pigmentary abnormalities, hyper-reflective foci in the outer nuclear layer and posterior shadowing can be found. Conversely, hypo-pigmentary changes may result in an increased transmission of the OCT signal.
Fundus autofluorescence imaging may show variable patterns. A wide range of patterns has been described in the literature including normal, minimal change, focal, patchy, linear, lacelike, reticular, speckled, focal confluent, focal plaque-like and scattered.
There are several different types of drusen that may be identified in patients with AMD, such as reticular pseuodrusen. It is important to be able to identify the presence of additional drusen subtypes as they may be associated with an increased risk of conversion to late AMD.
To review the imaging characteristics of pigmentary changes and/or to review the information on different drusen types, please click on the links at the bottom of the page.
Case Examples
Risk of Progression
In recent years, significant research has been undertaken in the area of age-related macular degeneration. One area particularly relevant here is the identification of clinical signs in a patient with intermediate AMD that predict an increased risk of progression to late AMD. These prognostic biomarkers are important as they allow clinicians to stratify and manage patients with AMD.
Find out more about these signs by clicking on the link below.
Differential Diagnosis
References
Ferris, CP. Wilkinson, AB, Chakravarthy, U. Chew, E. Csaky, K. Sadda, SR. (2013) Clinical Classification of Age-related Macular Degeneration, Ophthalmology, Volume 120, Issue 4, Pages 844-851.
Ly, A. Yapp, M. Nivison-Smith, L. Assaad, N. Hennessy, M. Kalloniatis, M. (2018) Developing prognostic biomarkers in intermediate age-related macular degeneration: their clinical use in predicting progression. Clin Exp Optom. 101(2):172-181.